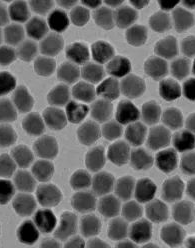
1703213362407722.png 微信截图_20230920143852.png

介孔硅包覆上转换发光材料,UCNPs@m-SiO2
发布时间:2023-12-22  作者:ssl  分享到:
介孔硅包覆上转换发光材料
介孔硅包覆上转换发光材料是指将上转换发光材料包裹在介孔硅(mesoporous silica)的外层,形成一种复合结构。介孔硅具有高度有序的孔道结构和大比表面积,这使得其在药物传递、生物医学成像等领域具有的应用前景。
药物传递: 介孔硅的孔道结构可以用于负载和释放药物。将上转换发光材料包裹在介孔硅中,可实现对药物的控制释放,具有潜在的药物传递应用。
生物医学成像: 上转换发光材料在近红外光谱范围内发光,适用于生物医学成像。将其包裹在介孔硅中可以增加其生物相容性,便于在体内应用。
保护作用: 介孔硅包裹层提供了额外的保护,可以防止上转换发光材料在特定环境中的溶解、氧化或与其他物质发生不良反应。
表面修饰: 介孔硅表面的官能团可以用于引入其他官能团,实现对上转换发光材料的表面修饰和功能化,例如生物分子的引入、物的连接等。
分散性提高: 介孔硅包裹层可以提高上转换发光材料的分散性,有助于在液体介质中的均匀分散。
多功能性: 复合结构赋予了材料更多的多功能性,可用于多个领域,包括生物医学、药物传递、生物传感等。
厂家:西安齐岳生物科技有限公司
用途:科研
状态:固体/粉末/溶液
产地:西安
保存:冷藏
温馨提醒:仅供科研,不能用于人体实验
相关产品:
绿光PEG修饰上转换纳米颗粒
NaYF4:Yb,Tm/Er稀土掺杂上转换发光颗粒
四氟硼酸亚硝修饰的上转换纳米粒子
LaF3:Yb/Er@NaYF4核壳上转换纳米颗粒
水溶性羧基化上转换纳米颗粒
核壳型羧基化绿光上转换纳米粒子
PEI修饰红光上转换纳米粒子




 齐岳微信公众号
齐岳微信公众号
 官方微信
官方微信
 库存查询
库存查询